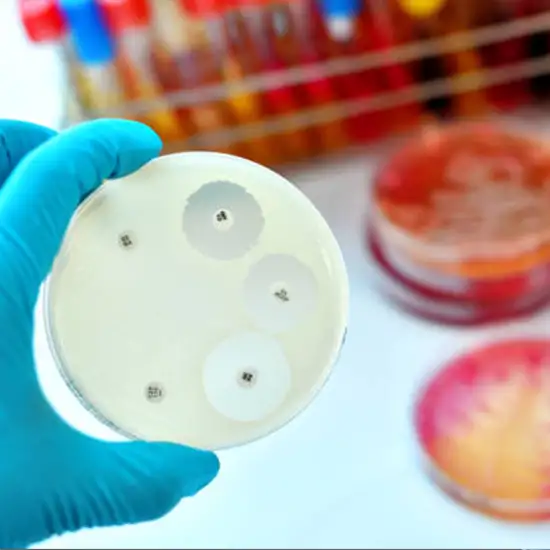

Book Streptomycin Drug Appointment Online Near me at the best price in Delhi/NCR from Ganesh Diagnostic. NABL & NABH Accredited Diagnostic centre and Pathology lab in Delhi offering a wide range of Radiology & Pathology tests. Get Free Ambulance & Free Home Sample collection. 24X7 Hour Open. Call Now at 011-47-444-444 to Book your Streptomycin Drug at 50% Discount.
TB Sensitivity (Streptomycin) is a test to see if a tuberculosis patient responds to streptomycin. Streptomycin is an antibiotic used to treat bacterial illnesses such as tuberculosis (TB). A sensitivity test, also known as a susceptibility test, assesses an antibiotic's ability to inhibit bacterial growth. The practitioner then selects whether or not to prescribe the medicine based on the sensitivity test results. Blood, urine, or sputum samples (spit).
TB Sensitivity (Streptomycin) is a test that determines whether or not streptomycin, an antibiotic, will kill TB bacteria.
You should go to a provider if you have any of the below signs from a streptomycin drug:
The lab technician will provide details.
No preparation is needed.
No care is required.
The Streptomycin Drug Test cost varies INR 2500 to INR 9000 by region and facility. So constantly get tested at trustworthy diagnostic centers like Ganesh Diagnostic. It is staffed by trained and experienced professionals to assure patient and visitor safety.
| Test Type | Streptomycin Drug |
| Includes | Drug Test for Streptomycin (Pathology) |
| Preparation | |
| Reporting | Within 24 hours* |
| Test Price |
₹ 3200
|

Early check ups are always better than delayed ones. Safety, precaution & care is depicted from the several health checkups. Here, we present simple & comprehensive health packages for any kind of testing to ensure the early prescribed treatment to safeguard your health.